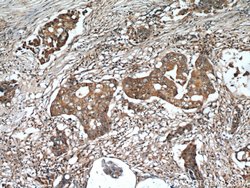
ADAM12 Rabbit anti-Human, Mouse, Polyclonal, Proteintech 20 &mu;L; Unconjugated:Antibodies,

missing translation for 'onlineSavingsMsg'
Learn More
Learn More
ADAM12 Rabbit anti-Human, Mouse, Polyclonal, Proteintech
Rabbit Polyclonal Antibody
Brand: Proteintech 14139-1-AP-20UL
This item is not returnable.
View return policy
Description
This antibody can recognize all isoforms of ADAM12. ADAM12 has 4 forms: 120 kDa full-length form, 90 kDa mature (processed form that lack the pro domain);50-68 kDa degradation product and 27 kDa pro domain.
ADAM12 is a member of the ADAM (a disintegrin and metalloprotease-like domain) family. Two forms of ADAM12 have been described: ADAM12S and ADAM12L (short and long forms). The short form is a soluble form lacking the transmembrane and cytoplasmic domains. The short form of ADAM12 was reported to provoke myogenesis, and the lack of cytoplasmic domain suggests different regulation pathways (although both forms can be expressed in the same tissue).Specifications
| ADAM12 | |
| Polyclonal | |
| Unconjugated | |
| ADAM12 | |
| ADAM 12, ADAM12, MCMP, MCMPMltna, Meltrin alpha, MLTN, MLTNA | |
| Rabbit | |
| Antigen Affinity Chromatography | |
| RUO | |
| 11489, 8038 | |
| -20°C | |
| Liquid |
| Immunocytochemistry, Immunofluorescence, Immunoprecipitation, Immunohistochemistry (Paraffin), Western Blot | |
| 0.26 mg/mL | |
| PBS with 50% glycerol and 0.02% sodium azide; pH 7.3 | |
| O43184, Q61824 | |
| ADAM12 | |
| ADAM12 Fusion Protein Ag5206 | |
| 20 μL | |
| Primary | |
| Human, Mouse | |
| Antibody | |
| IgG |
Product Content Correction
Your input is important to us. Please complete this form to provide feedback related to the content on this product.
Product Title
Spot an opportunity for improvement?Share a Content Correction